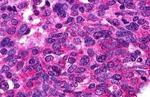
S1P1 Antibody in Immunohistochemistry (Paraffin) (IHC (P))

Search
Invitrogen
S1P1 Polyclonal Antibody
{{$productOrderCtrl.translations['antibody.pdp.commerceCard.promotion.promotions']}}
{{$productOrderCtrl.translations['antibody.pdp.commerceCard.promotion.viewpromo']}}
{{$productOrderCtrl.translations['antibody.pdp.commerceCard.promotion.promocode']}}: {{promo.promoCode}} {{promo.promoTitle}} {{promo.promoDescription}}. {{$productOrderCtrl.translations['antibody.pdp.commerceCard.promotion.learnmore']}}
产品信息
PA5-34181
种属反应
宿主/亚型
分类
类型
抗原
偶联物
形式
浓度
规格
纯化类型
保存液
内含物
保存条件
运输条件
RRID
产品详细信息
Percent identity with other species by BLAST analysis: Human, Platypus (100%).
靶标信息
S1P1 is a G-protein coupled receptor for the bioactive lysosphingolipid sphingosine 1-phosphate (S1P) that is coupled to the G(i) subclass of heteromeric G proteins. S1P1 signaling leads to the activation of RAC1, SRC, PTK2/FAK1 and MAP kinases. It plays an important role in cell migration via its role in the reorganization of the actin cytoskeleton and formation of lamellipodia in response to stimuli that increase the activity of the sphingosine kinase SPHK1. S1P1 is required for normal chemotaxis toward sphingosine 1-phosphate, normal embryonic heart development, and normal cardiac morphogenesis.
仅用于科研。不用于诊断过程。未经明确授权不得转售。
篇参考文献 (0)
生物信息学
蛋白别名: CD antigen CD363; CD363; CD363 antigen; EDG1; Endothelial differentiation G-protein coupled receptor 1; endothelial differentiation protein (edg-1); endothelial differentiation, sphingolipid G-protein-coupled receptor, 1; S1P receptor 1; S1P receptor Edg-1; similar to spleen endothelial differentiation gene EDG-1; Sphingosine 1-phosphate receptor 1; Sphingosine 1-phosphate receptor Edg-1; sphingosine 1-phosphate receptor EDG1; unnamed protein product
基因别名: CD363; CHEDG1; D1S3362; ECGF1; EDG-1; EDG1; S1P1; S1PR1
UniProt ID: (Human) P21453
Entrez Gene ID: (Human) 1901